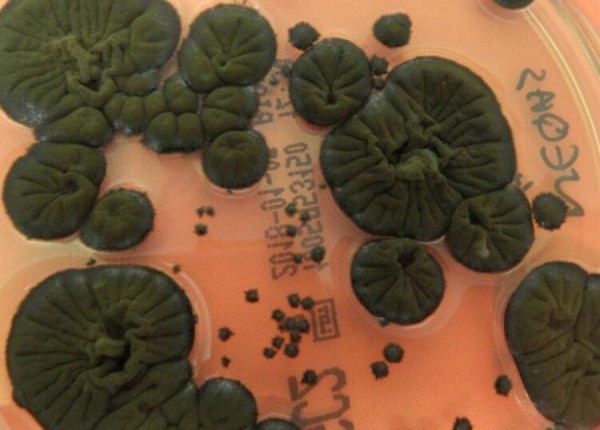
В Чернобыле происходит что-то странное - на АЭС обнаружен гриб, который питается радиацией и преобразует ее в энергию В Чернобыле происходит что-то странное - на АЭС обнаружен гриб, который питается радиацией и преобразует ее в энергию

В Чернобыле происходит что-то странное — на АЭС обнаружен гриб, который питается радиацией и преобразует ее в энергию

Зона отчуждения Чернобыльской АЭС, где 40 лет назад произошла авария на четвёртом энергоблоке, закрыта для людей, но природа там поистине процветает.
Несмотря на то, что изолированное место вселяет тревогу, различные организмы продолжают жить и развиваться. Более того, недавно рядом с разрушенным реактором был обнаружен новый тип необычного чёрного гриба, который питается высокой радиацией и преобразует её в энергию.

Гриб назвали Cladosporium sphaerospermum, он поселился во внутренних стенах одного из самых радиоактивных зданий на планете.
Он имеет опасно тёмный оттенок, так как богат меланином. Благодаря меланину гриб способен защищаться от ионизирующего излучения и расти под воздействием радиации (явление, известное как «радиосинтез»).
Ученые также обнаружили, что излучение совершенно безвредно для гриба. Однако радиация опасна для человека.
По данным Interesting Engineering, его использование может произвести революцию в исследовании космоса.
Чтобы проверить устойчивость организма, исследователи в 2022 году запустили Cladosporium sphaerospermum в космос и прикрепили его к внешней поверхности Международной космической станции (МКС). Там гриб получил полную дозу космической радиации. Сенсоры показали, что через слой гриба проникло меньше радиации, чем в обычной среде. Это означает, что он действует как естественный радиационный щит.

Оказалось, что на Международной космической станции гриб растет на 20% быстрее, чем в естественных условиях.
Ученые полагают, что этот гриб может быть использован в качестве биологического щита от радиации. Кроме того, Cladosporium sphaerospermum может иметь большое значение для космической отрасли, поскольку традиционные методы защиты — свинец и другие материалы — слишком тяжелые и дорогие.
Издание отмечает, что NASA уже изучает концепцию «микоархитектуры» — структур из грибного мицелия, способных к самовосстановлению и защите от радиации.
Группа исследователей начала изучать территорию вблизи реактора в конце 1990-х годов. Они обнаружили мини-экосистему 37 видов грибов. Почти все они были тёмного цвета, богаты меланином, а главным «резидентом» оказался Cladosporium sphaerospermum. Это самый радиоактивно загрязнённый образец.
На видео кадры, снятые внутри четвёртого реактора Чернобыльской АЭС: